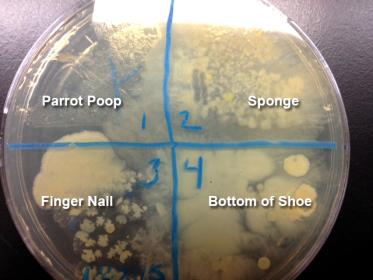

IF THIS SITE IS DOWN EMAIL SUPPORT@BLACKOPSHOSTING.COM
-
Posts
249 -
Joined
-
Last visited
Content Type
Profiles
Forums
Events
Gallery
Everything posted by bluedawg
-
Looking for 30 days of night on Netflix
-
-
from your post to you know who's ears - Mary
-
Hi Muse, I went out and bought a jug of white vinegar and I ordered a knitting book with dishcloth patterns I like Inara's idea of having one for every day of the week so they can be rotated in the laundry.
-
I vote for Crochet.
-
I am afraid Dave has gone off the farm.
-
OK, so here it is.... Nothing very spectacular but you can see where the parrot poop has far less growth than the rest... How do you guys insert a large image instead of thumbnail?
-
Hi Muse... No, I am in school for laboratory science. Right now I'm finishing up my associates in Math & Science then I'll continue on to get my bachelors in Laboratory science... or maybe I'll change my mind and go for the wildlife biology degree in any case I have microbiology lecture and lab tomorrow back to back so can't wait to look at my samples under the microscope. I'll bring home some pictures to post. They are not gross at all. It's just interesting to see how much less growth is in the poop than the rest. I would have expected to see more growth but I guess it makes sense - all types of creepy crawleys can grow in the sponge environment but in the intestines only a select few can live. I am going to have to identify the different bacteria types so that should be fun. Inara, I love your idea of knitting your own cloths, one for each day of the week... I am going to do that too. Also a great gift idea Do you have a pattern?
-
That is adorable. She missed you
-
You are not wrong. it's not completely safe... I wouldn't eat it. The distribution of E. coli in psittacines varies from one species to another. It is less common in Amazons and macaws, sometimes found in greys, and common in cockatoos and Eclectus. In fact, E. coli can compose as much as 30 percent of the gut flora of some psittacines and others like cockatiels and budgies carry somewhat less. While there was far less growth from the parrot poop than the other samples - that doesn't mean what is there is safe. I have not identified the different bacteria types yet - I will though
-

Parront medical health issues
bluedawg replied to kins2321@yahoo.com's topic in Off-Topic Discussions
DOooh, Sorry. I thought this was the topic. Didn't mean to hijack the thread! -
Oh yes, I have a taker! I will take some pictures on Saturday and share
-
Hmmm... Do I detect a tad bit of sarcasm in your response Dave?
-

Parront medical health issues
bluedawg replied to kins2321@yahoo.com's topic in Off-Topic Discussions
Wow, Nancy I am very sorry you had to go through that and I am sure you are still healing. You are lucky to have your son available to help. How are you making out? This post is very timely for me as I am going through a very stressful time. My mom has just been diagnosed with Mesothelioma and we are going to the city Tuesday to get the scoop from her surgeon. Of course I looked it up online which they say one should never do but one always does and it seams most people live about a year depending on a few things like cell type etc. I can't really bear the thought of loosing my mom. I was out of the house for 14 hours the day they did exploratory surgery on her and I worried about Miss Dayo but she was fine when I got home and didn't even seam upset with me. I am struggling right now trying to study for school stuff, going to work and being so distracted. Not to mention my own last scan came back with a swollen lymph node which needs to be rechecked in a month to make sure it has gone down. If not it would indicate my cancer has returned and my oncologist says at that point I would have stage 4 incurable cancer. That's kind of mind blowing. Going from cured to incurable. but I have not even thought about that for worrying about my mom. -
Chezron... Found this article http://www.rsc.org/Publishing/ChemTech/Volume/2009/03/solar_power_kills_bacteria.asp Looks like the Sun does kill bacteria. I am glad you are using glass though - Those people in developing countries leaving plastic bottles of water out in direct sun for hours have a whole different group of contaminants to worry about.
-
Chezron, That Sun thing is interesting... I will look into that
-
I havn't used my ceiling fan in 3 years since I got her... and since she has gotten used to landing on it and using it like a carnival ride I wouldn't take the chance. It is now a parrot toy
-
That is supposed to be the best way to go... The microwave method kills 99.9% of bacteria, except I don't use Microwaves... I'm leary of them
-
Miss Dayo was clipped when I got her so I let her wings grow out... then when I had to go in to the hospital for a week I made a tortured decision to clip her so she'd be safe for the week at a friend's house while I was gone. But as soon as I did it I knew it was the wrong decision. She was so depressed. She did not interact with her environment at all... just sat there looking sad. Oh and the pathetic attempts to fly were just more than I could bear. I vowed never to do that again. Better for her to stay in her cage for a week than to clip her wings. As far as keeping her safe (and my stuff safe) being fully flighted and un-caged, I have learned to use things that she is afraid of to keep her from getting into trouble. For instance beanie babies worked well for a while. I put them wherever I did not want her to go... worked like a charm. When one thing wears off I always stumble onto something else to use as a deterrent. Right now I have a T-Rex guarding my Ivy plants. Kitchen pots are always covered with one of those screen splatter guards.. just in case. As you work together and observe their behavior closely you will find a flighted parrot is manageable.
-
That's impressive!
-
Thought some here might be interested to know that, as per my microbiology experiment, there is far less bacteria in Parrot poop than is on your kitchen sponge. In fact last week I took samples from Parrot Poop, Kitchen Sponge, Bottom of my shoe and under my finger nail as well as nose and throat cultures, and this week after a week in the incubator the culture which showed the least growth was Parrot Poop Hurray for Parrot Poop! So you would do better to wash your dished with poop than with an old kitchen sponge. I can post a pic of the petri dish next week if anyone is interested to see Here's an enviro friendly method to kill those pesky bacteria on your kitchen sponge: Soak your sponge for at least 5 minutes in full-strength white vinegar — overnight is even better. Then, let the sponge air-dry — in the sun, if possible. The vinegar method kills 99.6% of bacteria from sponges.
-
LOL - I hear it's a bug that originated somewhere in Africa. Once you've got it you can never get rid of it. It can effect the keyboard, rubber gasket around the screen and the power cord. I have had all those things replaced on my computer since the issue started a few years ago. It's a chronic bug but it's manageable.
-
-
Oh wow - If it's really all vegetable then It'll be good for me too! I'll look for it - You can find everything on Amazon Doooh - I found it here: http://www.amazon.com/Wacky-Mac-Enriched-Spinach-Macaroni/dp/B00K5YK67I/ref=sr_1_fkmr0_1?ie=UTF8&qid=1423747577&sr=8-1-fkmr0&keywords=Wacky+Mac+vegetable+pasta But it's really just regular semolina pasta with vegetable powders in it. I'm sure Dayo will still love it.
-
You might try giving her a slice of Aloe to chew on. Sometimes they have it in the supermarket (Pic attached) I give Dayo a slice every now and then as a treat and the gooey center gets all over her feet and beak - it's very soothing and good for digestion. It might help Rikki's irritated mouth area.